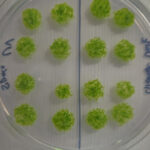
16 spores de mousse vert vif disposées en grille sur une boîte de Pétri transparente.

L'Orforglipron, un médicament GLP-1 pris sous forme de pilule, a obtenu des résultats positifs chez les personnes souffrant d'obésité et de diabète de type 2, bien qu'il semble moins efficace que les médicaments injectables.

Les comprimés pourraient offrir un moyen plus pratique de prendre des médicaments amaigrissants
Une pilule quotidienne pourrait bientôt être disponible comme alternative aux injections de Wegovy et Ozempic après qu'un essai ait révélé qu'elle entraînait une perte de poids substantielle et une amélioration de la glycémie chez les personnes souffrant d'obésité et de diabète de type 2.
L'Orforglipron, développé par la société pharmaceutique Eli Lilly, est conçu pour agir de la même manière que le sémaglutide, l'ingrédient actif de Wegovy et Ozempic, qui imite une hormone appelée GLP-1.
Un essai antérieur a révélé que l'orforglipron permettait aux personnes obèses mais sans diabète de type 2 de perdre environ 11 % de leur poids corporel, en moyenne, sur 72 semaines. C'est moins que les 15 pour cent généralement obtenus sur une période similaire avec le sémaglutide injectable, mais prendre le médicament sous forme de pilule est plus pratique, explique Deborah Horn de l'Université du Texas.
Pour déterminer si les personnes souffrant d'obésité et de diabète de type 2 pourraient également en bénéficier, elle et ses collègues ont recruté plus de 1 600 personnes atteintes des deux maladies dans 10 pays, dont l'Inde, l'Australie, la Chine, l'Allemagne, le Brésil et les États-Unis.
Ils ont assigné au hasard environ 900 participants à prendre quotidiennement une dose faible, moyenne ou élevée d’orforglipron. Les participants restants ont pris quotidiennement une pilule placebo et ont tous reçu des conseils sur leur mode de vie.
Après 72 semaines, ceux qui avaient reçu la dose élevée avaient perdu en moyenne près de 10 pour cent de leur poids corporel, 67 pour cent de ce groupe ayant perdu plus de 5 pour cent. Les groupes à dose moyenne et faible ont perdu environ 7 pour cent et 5 pour cent en moyenne, tandis que ceux sous placebo ont perdu moins de 3 pour cent.
Cela confirme que l'orforglipron entraîne moins de perte de poids que les médicaments injectables GLP-1, mais il peut néanmoins apporter des bénéfices pour la santé et la qualité de vie des personnes, explique Stefan Trapp de l'University College de Londres, qui n'a pas participé à l'étude. « Une perte de poids de seulement 5 pour cent tend à montrer des avantages très évidents : par exemple, les gens peuvent faire un peu plus d'exercice, modifier leur mode de vie, réduire le risque d'autres maladies », dit-il.
Les personnes prenant la dose élevée ont également constaté une réduction de leur taux de sucre dans le sang de près de 2 pour cent en moyenne, environ 75 pour cent d'entre elles atteignant les niveaux généralement visés par les patients diabétiques, explique Horn. Des bénéfices moindres ont été observés avec des doses plus faibles, et ceux qui prenaient le placebo ont vu leur taux de sucre dans le sang chuter de seulement 0,1 pour cent.
Environ un dixième des participants ayant reçu des doses élevées et moyennes ont dû arrêter de prendre le médicament en raison d'effets secondaires tels que des nausées, des vomissements et de la diarrhée, soit environ deux fois le taux observé dans les groupes à faible dose et sous placebo. Mais la plupart des participants ont trouvé que les effets secondaires étaient gérables, explique Horn. «Les effets secondaires étaient comparables à ceux d'autres médicaments (injectables) GLP-1», dit-elle.
Eli Lilly espère que le médicament sera approuvé par la Food and Drug Administration des États-Unis pour traiter l'obésité et le diabète de type 2 au début de l'année prochaine, a déclaré Horn. «En tant que médecin, j'espère que la FDA choisira d'approuver les trois doses afin que nous ayons la flexibilité de choisir la meilleure dose pour nos patients, qui optimise la santé et minimise les effets secondaires», dit-elle.
L'Orforglipron devrait être moins cher à fabriquer, à stocker et à livrer aux patients que les médicaments injectables GLP-1, car il ne nécessite ni réfrigération ni seringues, explique Trapp. Ceci, combiné au fait qu'il évite l'inconfort des injections, signifie que cela pourrait élargir l'accès aux médicaments amaigrissants GLP-1, qui sont actuellement chers et difficiles d'accès dans certains pays à revenu faible ou intermédiaire, dit-il.